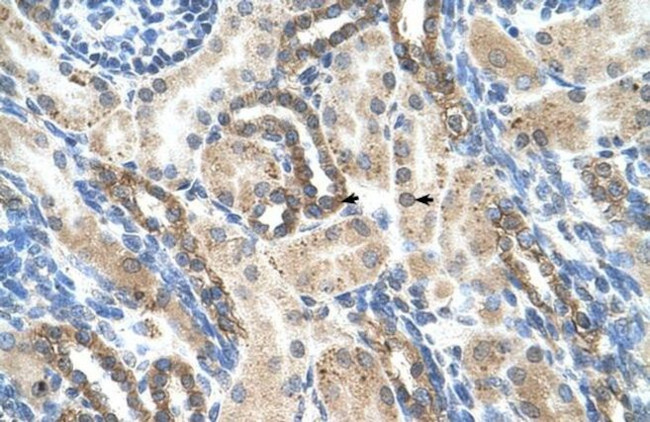
PSG1 Antibody in Immunohistochemistry (Paraffin) (IHC (P))

Search
Invitrogen
PSG1 Polyclonal Antibody
{{$productOrderCtrl.translations['antibody.pdp.commerceCard.promotion.promotions']}}
{{$productOrderCtrl.translations['antibody.pdp.commerceCard.promotion.viewpromo']}}
{{$productOrderCtrl.translations['antibody.pdp.commerceCard.promotion.promocode']}}: {{promo.promoCode}} {{promo.promoTitle}} {{promo.promoDescription}}. {{$productOrderCtrl.translations['antibody.pdp.commerceCard.promotion.learnmore']}}


Please note: We are reviewing Western blot images included in the antibody testing data in our catalog, including those provided by third parties. Unless expressly labeled or annotated as “raw-unedited”, Western blot images included in the antibody testing data in our catalog may have been edited, optimized or otherwise adjusted for presentation.
产品信息
PA5-42144
种属反应
宿主/亚型
分类
类型
抗原
偶联物
形式
浓度
规格
纯化类型
保存液
内含物
保存条件
运输条件
RRID
产品详细信息
Peptide sequence: SGRETAYSNA SLLIQNVTRE DAGSYTLHII KGDDGTRGVT GRFTFTLHLE
Sequence homology: Human: 100%
靶标信息
Human pregnancy-specific glycoproteins (PSG), are a group of closely related secreted glycoproteins which are highly expressed in placental syncytiotrophoblast cells of fetal origin. PSG are commonly expressed in tumors of trophoblast origin (hydatidiform mole, choriocarcinoma). They represent the most abundant fetal protein in the maternal blood at term. The eleven human PSG genes (PSG1-PSG11) form together with the carcinoembryonic antigen (CEA)-related cell adhesion molecule (CEACAM) genes the CEACAM gene family. PSG stimulates secretion of TH2-type cytokines from monocytes. CD9 was shown to represent the monocyte receptor for murine PSG17. PSG are thought to modulate the maternal immune system during pregnancy thus protecting the semiallotypic fetus from rejection.
仅用于科研。不用于诊断过程。未经明确授权不得转售。
篇参考文献 (0)
生物信息学
蛋白别名: carcinoembryonic antigen SG9; CD66 antigen-like family member F; CD66f; Fetal liver non-specific cross-reactive antigen 1/2; fetal liver non-specific cross-reactive antigen precursor protein; fetal liver non-specific cross-reactive antigen-2 precursor protein; FL-NCA-1/2; FLJ90598; FLJ90654; pegnancy-specific beta-1-glycoprotein precursor; pregnancy-specific B-1 glycoprotein; Pregnancy-specific beta-1 glycoprotein C/D; pregnancy-specific beta-1-glycoprotein; Pregnancy-specific beta-1-glycoprotein 1; pregnancy-specific beta-glycoprotein c; pregnancy-specific beta-glycoprotein d; pregnancy-specific glycoprotein; pregnancy-specific glycoprotein-1a; pregnancy-specific glycoprotein-1d; PS-beta-C/D; PS-beta-G-1; PSG 1; PSG IIA-d; PSG-1d; PSG1; PSG95; PSGIIA-a; PSGIIA-b; PSGIIA-c; SP 1; unnamed protein product
基因别名: B1G1; CD66f; FL-NCA-1/2; PBG1; PS-beta-C/D; PS-beta-G-1; PSBG-1; PSBG1; PSG1; PSG95; PSGGA; PSGIIA; SP1
Entrez Gene ID: (Human) 5669